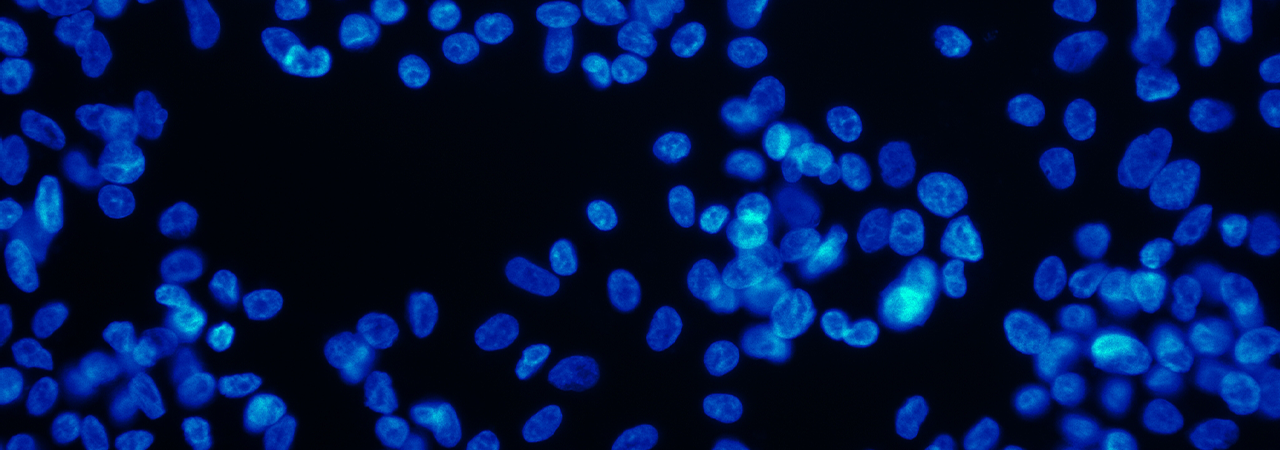

Nouveau partenariat entre Swiss Medical Network et GE HealthCare
Swiss Medical Network et GE HealthCare ont conclu un partenariat stratégique pour faire progresser l’imagerie moléculaire et la médecine théranostique. Leur objectif commun est de fournir des technologies innovantes pour une oncologie personnalisée.